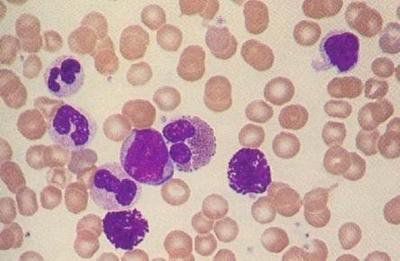
科普宣教 | 什么是急性淋巴细胞白血病? 科普宣教 | 什么是急性淋巴细胞白血病?

什么是急性白血病
急性淋巴细胞白血病(ALL)是急性白血病的一种类型,指的就是白血病细胞起源于淋巴系统,包括像原始和幼稚的淋巴细胞,又具体的分为B急性淋巴白血病和T细胞的急性淋巴白血病;多见于儿童及青年人。
目前无论是急性白血病还是慢性白血病,发病原因不是很清楚,可能和病毒感染、电离辐射、化学物品都是有关系的,但是确切的病因不清楚,也就是目前ALL找不到什么原因导致的,但是如果平时进行适当的体育锻炼,规律作息以及规律饮食,对预防各种疾病都是有好处的。

3.遗传因素:
某些遗传性疾病常伴较高的白血病发病率(多数具有染色体畸变和断裂)。如唐氏综合征易发急性粒细胞白血病和急性淋巴细胞白血病,比正常儿童患病几率高约15-20倍。

4.病毒因素:
某些病毒确定与淋巴细胞白血病有关,例如人类嗜T细胞病毒(HTLV)和EB病毒(EBV)。


急性淋巴细胞白血病临床表现有哪些?
患者常突感畏寒、发热、头痛、乏力、衰竭、食欲不振、恶心、呕吐、腹痛、腹胀,常有皮肤、鼻、口腔、齿龈出血,严重者可有呕血、便血、尿血、眼底及颅内出血等,并出现进行性贫血,发展极为迅速。其特点包括:
(1)一般症状:起病急骤,多数患者以发热、进行性贫血、出血或骨关节疼痛为特点。
(2)发热:主要原因是感染,常见于呼吸道、泌尿系统、肛周等,往往感染灶不明显,严重者可致败血症。


(3)出血:出血部位可遍及全身,以皮下、口腔、鼻腔为最常见。颅内出血、消化系统、呼吸道大出血可致死亡。


(4)贫血:患者在早期即可出现面色苍白、心悸、乏力、呼吸困难等。


急性淋巴细胞白血病要进行哪些临床检查?
(1)血象白细胞计数多增高,可见幼稚淋巴细胞及异型淋巴细胞。血小板正常或减少。


(2)骨髓象增生活跃至极度活跃,幼稚和原始淋巴细胞占25%以上。

(3)流式细胞仪检查:确定细胞免疫表型
急性淋巴细胞白血病(ALL)必选抗体

急性B淋巴细胞白血病(B-ALL)亚型分类

急性T淋巴细胞白血病(T-ALL)亚型分类

(4)染色体和基因检查:
A、Ph1染色体检查,有助于确诊并指导治疗和预后。


B、PCR-基因分型:
1.43种融合基因筛查+WT1定量;
2.定量BCR-ABL(P210,P190,P230);
3.T-ALL定性PCR:1P32染色体内微缺失SIL/TAL1;
4.Ph-like ALL 相关33种融合基因筛查。
C、FISH-基因分型:
1.儿童ALL-FISH:BCR/ABL,TEL/AML,MLL,MYC,10.4,P53
2.成人ALL-FISH:BCR/ABL,MLL,IGH,MYC,P16,P53。
出现上述情况,立即到医院就诊!把问题交给专科医生解决。
根据病史、临床表现、血象和骨髓象、流式细胞学、染色体和基因等可以明确诊断。
ALL应与哪些疾病进行鉴别?
1.类白血病反应:外周血白细胞增多显著增多和(或)出现幼稚白细胞者称为类白血病反应,通常有感染中毒、肿瘤、失血、溶血药物等原因,NAP积分显著增高,去除诱因后类白血病反应即可恢复正常,红细胞及血小板不受影响,难与白血病鉴别此时,可辅以免疫遗传等方法仔细区别。
2.再生障碍性贫血:本病出血贫血、发热和全血减少与白细胞减少的ALL相似,易与低增生性白血病混淆,本病肝、脾淋巴结不肿大,骨髓增生低下而无原始幼稚细胞比例增高现象。
3.恶性组织细胞病:本病是单核-巨噬细胞系统恶性增殖性疾病临床上可出现发热贫血出血肝、脾和淋结肿大以及全身广泛浸润性病变,很难与白血病鉴别。如果见到大量吞噬型组织细胞且出现一般异常组织细胞,则支持诊断本病。恶性组织细胞增生症,缺乏特异性诊断手段,骨髓象支持而临床不符合者不能诊断,反之临床支持而骨髓象不符合者,不能排除诊断。所以本病依靠综合分析。骨髓及淋巴结活检可提供一定证据。
4.传染性单核细胞增多症:本症为EB(Epstein-Barr)病毒感染所致临床有发热,皮疹咽峡炎,肝脾淋巴结肿大;血象白细胞增高以淋巴细胞升高为主,且变异淋巴细胞常达10%以上。
5.风湿与类风湿关节炎:发热、关节痛贫血白细胞增高等与ALL类似,但肝、脾、淋巴结多不肿大,行骨髓检查则不难区别。
6.骨髓增生异常综合征(myelo dysplastic syndrome,MDS): 是一组因造血干细胞受损而致骨髓病态造血和功能紊乱性疾病本病以贫血为主要表现,可伴有不同程度的出血、肝脾、淋巴结肿大,少数病例还有骨痛。有20%~30%的病例最终转变成急性白血病,本症骨髓象呈现三系或二系或任一系的病态造血。
如果得了急性淋巴细胞白血病,最主要的是给予积极的治疗,包括全身化疗,部分患者需要做造血干细胞移植治疗,有一部分或者一少部分急性淋巴白血病是可以治愈的,因此应该给予积极的治疗。
急性淋巴细胞白血病的来源不同,预后也不同,相对来说,B细胞的急性淋巴细胞白血病要比T急性淋巴细胞白血病预后要好一些,而且急性淋巴细胞白血病多见于儿童。儿童急性淋巴细胞白血病也是预后相对较好的一种急性白血病。




